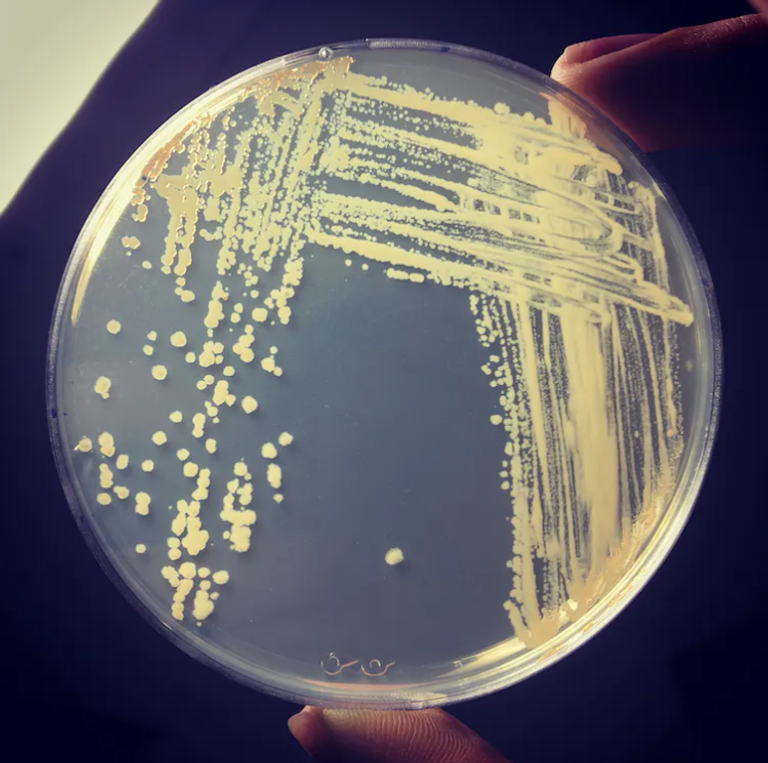
بكتيريا " المتفطرة اللخنية "

تحويل الهواء إلى كهرباء.."العين الإخبارية" تكشف تفاصيل "بديل الطاقة الشمسية" (حوار)
قد يبدو الأمر مفاجئا، ولكنه حقيقة، فعندما تكون الأوقات صعبة ولا يتوفر طعام آخر، يمكن لبعض بكتيريا التربة أن تحصل على الهيدروجين من الهواء، وتستخدمه كمصدر للطاقة.
وخلال الدراسة المنشورة في دورية "نيتشر"، قام فريق بحثي من جامعة موناش الأسترالية، بعزل الإنزيم الذي يمكّن بعض البكتيريا من استهلاك الهيدروجين واستخراج الطاقة منه، ووجدوا أنه يمكن أن ينتج تيارا كهربائيا مباشرة عند تعرضه حتى لكميات ضئيلة من الهيدروجين.
وقال الفريق خلال الدراسة، إنه قد يكون لهذا الإنزيم إمكانات كبيرة لتشغيل الأجهزة الصغيرة والمستدامة التي تعمل بالطاقة الهوائية في المستقبل.. فكيف توصل الفرق البحثي لهذا الاكتشاف، وما إمكانية استغلاله تطبيقيا، هذه الأسئلة وغيرها يجيب عنها كريس جرينينج، أستاذ علم الأحياء الدقيقة بجامعة موناش، في حوار خاص مع "العين الإخبارية":
بداية: من أين جاءتكم الفكرة التي قادت لاكتشاف هذا الإنزيم؟
تزيل البكتيريا في التربة 70 مليون طن من الهيدروجين سنويا من الغلاف الجوي، وهي عملية تشكل حرفياً تركيبة الهواء الذي نتنفسه، لذلك قمنا بتحليل الشفرة الجينية لبكتيريا التربة المسماة "متفطرة لخنية"، والتي تستهلك الهيدروجين من الهواء، ووجدوا أن إنزيما يسمى "هيدروجيناز" يساعد في ذلك.
كيف يقوم الإنزيم بهذا الدور؟
بداية يجب معرفة أن الهيدروجين أبسط جزيء، وهو مكون من بروتونين موجبي الشحنة متماسكين معا بواسطة رابطة من إلكترونين سالبي الشحنة، ووظيفة الإنزيم أن يكسر هذه الرابطة، مما يؤدي إلى إطلاق الإلكترونات، وفي البكتيريا، تتدفق هذه الإلكترونات الحرة إلى دائرة معقدة تسمى "سلسلة نقل الإلكترون"، ويتم تسخيرها لتزويد الخلية بالطاقة، والإلكترونات المتدفقة هي ما تتكون منه الكهرباء، مما يعني أن إنزيم (الهيروجينار) يحول الهيدروجين مباشرة إلى تيار كهربائي.
ويمثل الهيدروجين (0.00005) في المائة فقط من الغلاف الجوي، ويعد استهلاك هذا الغاز بهذه التركيزات المنخفضة تحديا هائلا لا يمكن لأي محفز معروف تحقيقه، وعلاوة على ذلك، فإن الأكسجين المتوفر بكثرة في الغلاف الجوي، يسمم نشاط معظم المحفزات المستهلكة للهيدروجين، لذلك فإن هذا الإنزيم بتغلبه على تلك التحديات، يقوم بدور مهم.
وكيف تمكنتم من معرفة الآلية التي يتغلب بها الإنزيم على هذه التحديات؟
شرعنا في عزله عن خلايا البكتيريا، وكانت عملية القيام بذلك معقدة، حيث قمنا أولا بتعديل الجينات التي تسمح للبكتيريا بصنع هذا الإنزيم، وعند القيام بذلك أضفنا تسلسلا كيميائيا محددا إلى الإنزيم، مما سمح لنا بعزله عن خلايا البكتيريا، ومع عزل الإنزيم، شرعنا في دراسته بجدية، لاكتشاف ما يمكن أن يفعله بالضبط، وكيف يمكن تحويل الهيدروجين الموجود في الهواء إلى مصدر مستدام للكهرباء.
وهذا الأمر لم يكن سهلا، حيث استغرق عدة سنوات وعدة طرق تجريبية قبل أن نتمكن من عزل عينة عالية الجودة من الإنزيم، الذي كان مستقرا للغاية، ويقاوم درجات الحرارة من 80 ℃ إلى –80 دون فقدان النشاط.
وماذا وجدتم عند عزله؟
وجدنا أنه حتى عند عزله عن البكتيريا، يمكن أن يستهلك الإنزيم الهيدروجين بتركيزات أقل بكثير حتى من الآثار الصغيرة في الهواء، وفي الواقع، لا يزال الإنزيم يستهلك نفحة من الهيدروجين أضعف من أن يكتشفها (كروماتوغراف الغاز) لدينا، وهي أداة شديدة الحساسية نستخدمها لقياس تركيزات الغاز، ووجدنا أيضا أن الإنزيم غير مقيّد تماما بالأكسجين، وهي خاصية لم تظهر في المحفزات الأخرى المستهلكة للهيدروجين، ولتقييم قدرته على تحويل الهيدروجين إلى كهرباء، استخدمنا تقنية تسمى الكيمياء الكهربائية، وأظهرت أن الإنزيم يمكنه تحويل تركيزات دقيقة من الهيدروجين في الهواء مباشرة إلى كهرباء، والتي يمكنها تشغيل دائرة كهربائية، وهذا إنجاز رائع وغير مسبوق لمحفز مستهلك للهيدروجين.

وما الفائدة التطبيقية لهذا الاكتشاف؟
هذا الإنزيم يمكن أن تكون لديه إمكانات كبيرة في تطوير أجهزة صغيرة ومستدامة تعمل بالطاقة الهوائية كبديل للطاقة الشمسية، لكن لا يزال أمامنا الكثير حتى نصل لهذه المرحلة.
ومتى يمكن الوصول لهذه المرحلة؟
المنتج من الإنزيم الآن هي كميات معملية لا تتعدي المليغرام، لكن حتى يكون الأمر تجاريا، يجب إنتاج كيلوغرامات، وهذا يحتاج لأبحاث أخرى للوصول لهذا المستوى.
aXA6IDIxNi43My4yMTYuMTU4IA== جزيرة ام اند امز